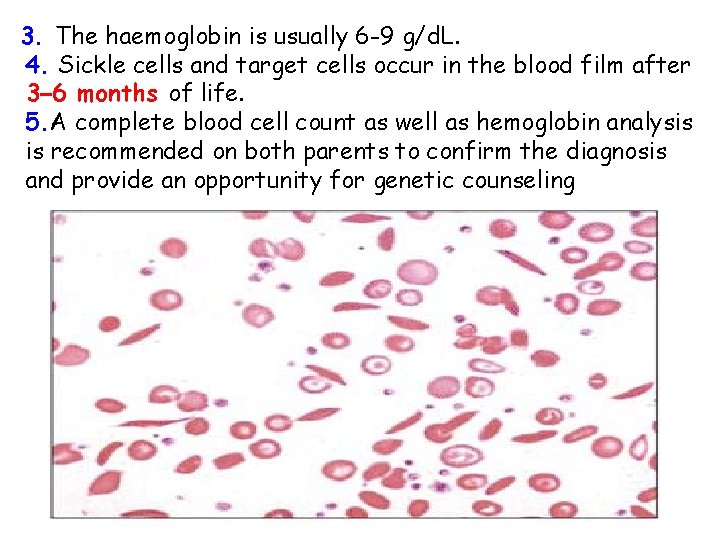
3. The haemoglobin is usually 6 -9 g/d. L. 4. Sickle cells and target

Hemoglobinopathies Hemoglobin is a tetramer consisting of 2

Hemoglobinopathies

Hemoglobin is a tetramer consisting of 2 pairs of globin chains. Abnormalities in these proteins are referred to as hemoglobinopathies

Two hemoglobin gene clusters are involved in the production of hemoglobin and are located at the end of the short arm of chromosomes 16 and 11, respectively. On chromosome 16, there are 3 genes within the alpha (α) gene cluster: zeta (ζ) and 2 α genes (α 1, α 2). On chromosome 11, there are 5 genes within the beta (β) gene cluster: epsilon (ε), delta (δ), beta (β), and 2 gamma (γ) genes.

Hemoglobin Types o. Embryonic hemoglobins( Gower-1 (α 2ε 2), and Portland (ζ 2γ 2)) o. Hb F (α 2γ 2) o. Hb. A (α 2β 2) o. Hb. A 2 (α 2δ 2) (ζ 2ε 2), Gower-2 The final hemoglobin distribution pattern that occurs in childhood is not achieved until at least 6 mo of age, and sometimes later. The normal hemoglobin pattern is >95% Hb A ≤ 3. 5 Hb A 2 <2. 5% Hb F


Sickle Cell Disease

Sickle Cell Disease Hemoglobin S (Hb S) is the result of a single base pair change, thymine for adenine, at the 6 th codon of the βglobin gene. This change encodes valine instead of glutamine in the 6 th position in the β-globin molecule.




ys a d 0 2 0 1

TYPES 1. Sickle cell anemia Homozygous state for Hb. S (βs βs) >70% Hb is Hb. S 2. Sickle cell trait Heterozygous carrier state for Hb. S (βs β) 25 -40% of Hb is Hbs 3. Sickle cell – β thalessemia Double heterozygote in which sickle cell gene is inherited from one parent and beta thalessemia gene from other parent (βs β 0) or (βs β+)

SICKLE CELL ANEMIA (HOMOZYGOUS HEMOGLOBIN S) CLINICAL MANIFESTATIONS AND TREATMENT vaso-occlusive episode is the cardinal clinical feature of sickle cell anemia , The pain may occur in any part of the body, but most often occurs in the chest, abdomen, or extremities. These painful episodes are often abrupt. The pathogenesis of pain is disruption of blood flow in the microvasculature by sickle cells, resulting in tissue ischemia. Precipitating causes of painful episodes can include physical stress, infection, dehydration, hypoxia, systemic acidosis, exposure to cold, and swimming in non-heated water for prolonged periods. Successful treatment of painful episodes include the use of acetaminophen or a nonsteroidal agent early in the course of pain, followed by acetaminophen with codeine and short- or long-acting oral opioids, or hospitalization with IV administration of morphine or morphine derivatives. Hydroxyurea, a myelosuppressive agent, is the only effective drug proven to reduce the frequency of painful episodes. Hydroxyurea raises the level of Hb F and the hemoglobin level.


It is able to block the sickling action of the RBCs so infants who have inherited the disease do not develop symptoms. People with sickle cell gene who continue to carry some Hb. F are better protected from severe form of the disease.

Dactylitis, often referred to as hand-foot syndrome, is frequently the 1 st manifestation of pain in children with sickle cell anemia, presents with symmetric swelling of the hands and/or feet. Unilateral dactylitis can be confused with osteomyelitis and requires careful consideration because treatment of the former requires palliation with pain medication, often acetaminophen with codeine, whereas osteomyelitis requires at least a 4– 6 wk course of IV antibiotics.

If Salmonella or Staphylococcus bacteremia occurs, strong consideration should be given to evaluation of osteomyelitis with a bone scan or an MRI, given the higher risk of osteomyelitis in children with sickle cell anemia compared with the general population.

Infections By 5 yr of age, most children have functional asplenia. Regardless of age, all patients with sickle cell anemia are at increased risk for infection and death as a result of bacterial infection, particularly with encapsulated organisms, such as Streptococcus pneumoniae and Haemophilusinfluenzae type B. Children with sickle cell anemia should receive prophylactic oral penicillin V (125 mg twice daily up to age 3 yr, then 250 mg twice daily). An alternative for children who are allergic to penicillin is erythromycin 10 mg/kg twice daily. In addition to penicillin prophylaxis, routine childhood immunizations and annual administration of influenza vaccine are highly recommended. management of fever in a child with sickle cell anemia is a medical emergency that requires prompt medical evaluation and antibiotics because of the high risk of bacterial infection , parenteral long-acting 3 rd-generation cephalosporin. For patients with a positive blood culture, pathogenspecific therapy (1 st empirically, then based on sensitivities) must be initiated.

Acute splenic sequestration is a life-threatening complication occurring primarily in infants, and may occur as early as 5 wk of age. The etiology of splenic sequestration episodes is unknown. Clinically, these events are associated with engorgement of the spleen, with a subsequent increase in spleen size, evidence of hypovolemia, and a decline in hemoglobin. These events can be accompanied by upper respiratory tract infections, bacteremia, or viral infection. Treatment maintenance of hemodynamic stability with either isotonic fluid or blood transfusions. Repeated episodes of splenic sequestration are common, occurring in approximately 50% of patients. Prophylactic splenectomy performed after the acute episode has resolved is the only effective strategy for prevention of future life-threatening episodes.

Acute chest syndrome (ACS) fever, respiratory distress, and pain that often occurs in the chest, but may include only the back and/or the abdomen. Even when no respiratory symptoms are present, all patients with fever should receive a chest radiograph to identify ACS. Radiographs may show single-lobe involvement, most often the left lower lobe, and when multiple lobes are involved, usually both lower lobes are affected. Pleural effusions, either unilateral or bilateral, may not be present initially (or may be minimal in size), but may progress rapidly to a total whiteout.

Treatment -oxygen administration, Oxygen should be administered when the oxygen saturation is <90%. -simple or exchange blood transfusion therapy. -opioids. -As a result of the clinical overlap between pneumonia and ACS, all episodes should be treated promptly with antimicrobial therapy that includes at least a macrolide and a 3 rd-generation cephalosporin to treat the most common pathogens associated with ACS ( S. pneumoniae Mycoplasma pneumoniae Chlamydia pneumoniae

Neurologic complications Approximately 11% and 20% will have either overt or silent strokes, respectively, before their 18 th birthday. Treatment of stroke includes - oxygen administration to maintain oxygen saturation at >96% - simple blood transfusion therapy to increase the hemoglobin to a maximum of 11. 0 g/d. L, exceeding this hemoglobin threshold may limit oxygen delivery to the brain because hyperviscosity of the blood may decrease oxygen delivery.

Human parvovirus B 19 Any child with reticulocytopenia should be considered as having parvovirus B 19 until proven otherwise. Acute infection with parvovirus B 19 is usually associated with red cell aplasia (aplastic episode). Treatment requires packed red blood cell transfusions for hemodynamic instability. Priapism, a common problem in sickle cell anemia, is an involuntary penile erection lasting longer than 30 min. Treatment of priapism is supportive therapy, such as a sitz bath or pain medication. If the priapism lasts longer than 4 hr, then aspiration of blood from the corpora cavernosa, followed by irrigation with dilute epinephrine. For the prevention of recurrent priapism, hydroxyurea is effective.

Renal disease Seven sickle cell anemia nephropathies have been identified: (1) gross hematuria (2) papillary necrosis, (3) nephrotic syndrome, (4) renal infarction, (5) hyposthenuria, (6) pyelonephritis, and (7) renal medullary carcinoma. The presentation of these entities may include hematuria, proteinuria, renal insufficiency, concentrating defects, or hypertension. other significant complications include • sickle cell retinopathy • delayed onset of puberty • avascular necrosis of the femoral head and humerus • leg ulcers

DIAGNOSIS OF SICKLE CELL DISEASE 1. In utero: Sickle cell disease can be diagnosed accurately in utero by mutation analysis of DNA by polymerase chain reaction (PCR) prepared from chorionic villus biopsy or fetal fibroblasts (obtained by amniocentesis). These techniques should be employed before 10 weeks’ gestation. 2. During newborn period: The diagnosis of sickle cell disease can be established by Hemoglobin electrophoresis : Sickle cell anemia Hb. S : 80 -95 % Hb. F : 5 -15% Hb. A 2: Normal
3. The haemoglobin is usually 6 -9 g/d. L. 4. Sickle cells and target cells occur in the blood film after 3– 6 months of life. 5. A complete blood cell count as well as hemoglobin analysis is recommended on both parents to confirm the diagnosis and provide an opportunity for genetic counseling

6. Sickle solubility tests depend on the decreased solubility of deoxygenated hemoglobin S. It is positive in patients with both sickle trait and sickle cell anemia and therefore cannot be used to distinguish homozygous from heterozygous hemoglobin S. ➪ Fetal hemoglobin interferes with polymerization of hemoglobin S, and the sickle solubility test can give a false-negative result if hemoglobin F makes up more than ~10 to 20% of hemoglobin in the sample. Therefore, the sickle solubility test is not reliable in infants during the first few months of life.

Sickle Cell Trait (Hb AS) The amount of Hb S in individuals with sickle cell trait is <50%. The life span of people with sickle cell trait is normal, and serious complications are very rare. The complete blood count is within the normal range. Hemoglobin analysis is diagnostic, revealing a predominance of Hb A, typically >50%. Complications of sickle cell trait include - sudden death during rigorous exercise - splenic infarcts at high altitude - hematuria, hyposthenuria, and bacteriuria - susceptibility to eye injury with formation of a hyphema - renal medullary carcinoma. Treatment is supportive. -Transfusion may be required during hemolytic episodes in severe cases. -oxidative drugs should be avoided, - folate supplementation.
- Slides: 28